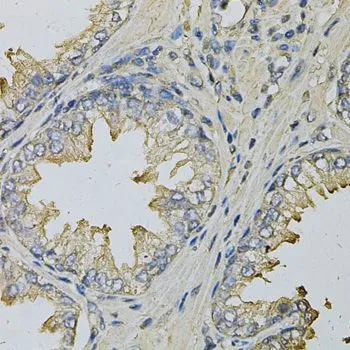

WB analysis of normal (control) and knockout (KO) HeLa cell lysate using GTX54315 LITAF antibody. Dilution : 1:1000 Loading : 25microg per lane
LITAF antibody
GTX54315
ApplicationsWestern Blot, ImmunoHistoChemistry, ImmunoHistoChemistry Paraffin
Product group Antibodies
TargetLITAF
Overview
- SupplierGeneTex
- Product NameLITAF antibody
- Delivery Days Customer7
- Application Supplier NoteWB: 1:500 - 1:2000. IHC-P: 1:50 - 1:200. *Optimal dilutions/concentrations should be determined by the researcher.Not tested in other applications.
- ApplicationsWestern Blot, ImmunoHistoChemistry, ImmunoHistoChemistry Paraffin
- CertificationResearch Use Only
- ClonalityPolyclonal
- ConjugateUnconjugated
- Gene ID9516
- Target nameLITAF
- Target descriptionlipopolysaccharide induced TNF factor
- Target synonymsPIG7, SIMPLE, TP53I7, lipopolysaccharide-induced tumor necrosis factor-alpha factor, LPS-induced TNF-alpha factor, lipopolysaccharide-induced TNF-alpha factor, p53-induced gene 7 protein, small integral membrane protein of lysosome/late endosome, small integral membrane protein of the late endosome, tumor protein p53 inducible protein 7
- HostRabbit
- IsotypeIgG
- Protein IDQ99732
- Protein NameLipopolysaccharide-induced tumor necrosis factor-alpha factor
- Scientific DescriptionLipopolysaccharide is a potent stimulator of monocytes and macrophages, causing secretion of tumor necrosis factor-alpha (TNF-alpha) and other inflammatory mediators. This gene encodes lipopolysaccharide-induced TNF-alpha factor, which is a DNA-binding protein and can mediate the TNF-alpha expression by direct binding to the promoter region of the TNF-alpha gene. The transcription of this gene is induced by tumor suppressor p53 and has been implicated in the p53-induced apoptotic pathway. Mutations in this gene cause Charcot-Marie-Tooth disease type 1C (CMT1C) and may be involved in the carcinogenesis of extramammary Pagets disease (EMPD). Multiple alternatively spliced transcript variants have been found for this gene. [provided by RefSeq, Dec 2014]
- Storage Instruction-20°C or -80°C,2°C to 8°C
- UNSPSC12352203